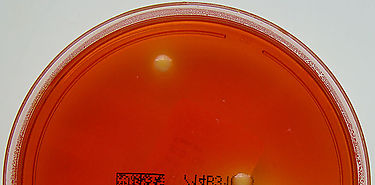
No han entrado en Panamá productos contaminados con Salmonella Reading No han entrado en Panamá productos contaminados con Salmonella Reading

Los alimentos ricos en vitamina E alargan y mejoran la calidad de vida

La ingesta de alimentos ricos en vitamina E retrasa el envejecimiento de las células y tejidos, así como de los órganos vitales, según un nuevo estudio. En la actualidad, la principal fuente de esta vitamina se obtiene de forma natural con el consumo de aceite de oliva virgen extra, pescado azul, verduras, frutos secos, huevos o cereales integrales. Su consumo previene la aparición de enfermedades crónicas asociadas al envejecimiento.
AUPSA fortalece su capacidad de análisis de alimentos

AUPSA tiene como función primordial velar para que los alimentos importados que ingresen al país cumplan con las normas sanitarias y fitosanitarias.

07 ene
MIDA fortalece sus servicios a través de la implementación y certificación de los Laboratorios Regionales...
02 ene
La Autoridad Panameña de Seguridad de Alimentos (AUPSA), en seguimiento a la alerta emitida por el Servicio...

02 ene
Los nuevos hallazgos de las investigaciones realizadas por el CDC y la FDA de los Estados Unidos ante...

02 ene
Una mayor ingesta diaria de vegetales de hoja verde ayuda a reducir la acumulación de grasa en el hígado...
ÚltimaHora

21:19 05 septiembre 2025
Nestlé Purina presenta el Desafío Clínico Pro Plan para impulsar la nutrición veterinaria basada en evidencia16:52 02 septiembre 2025
Ciudad de Panamá recibirá 150 especialistas mundiales en temas...22:24 05 junio 2025
Zafra 2025: Varela Hermanos alcanza el mayor rendimiento agrícola...18:11 17 marzo 2025
Medidas arancelarias en Estados Unidos:¿Existen soluciones para...








